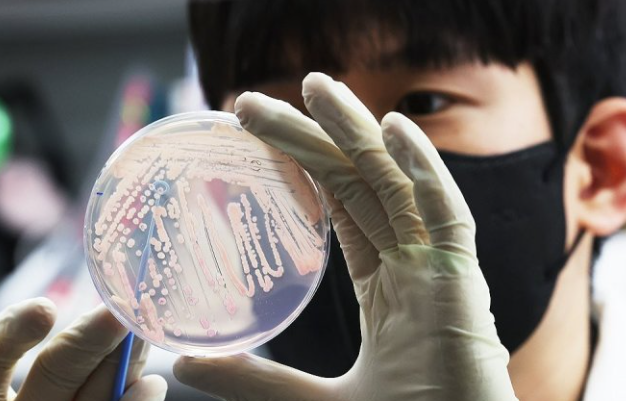
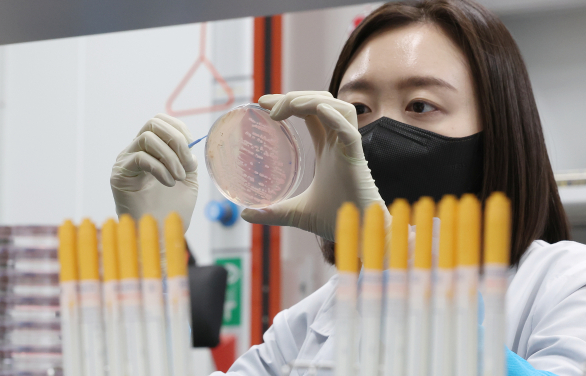
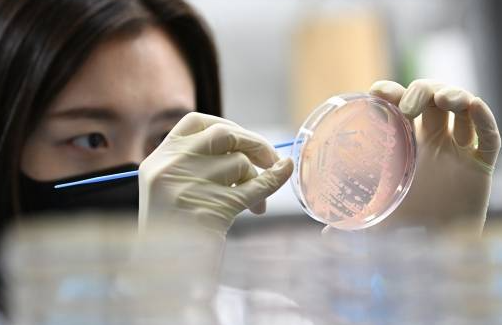

풀무원 빵 식중독?! 전국 환자 지도·회수 제품 체크리스트 꼭 확인

1. 식중독 풀무원 빵 회수 제품 리스트(딸기크림,초코바나나빵)


| 제품명 | 소비기한 | 중량 포장 | 제조사 | 유통사 | 회수 사유 |
| 고칼슘 딸기크림 롤케이크 | 2025-10-12 | 35 g × 낱개포장 | ㈜마더구스 | 풀무원 푸드머스 | 살모넬라균 검출 |
| 고칼슘 우리밀 초코바나나빵 | 2025-09-21 | 40 g × 낱개포장 | ㈜마더구스 | 풀무원 푸드머스 | 살모넬라균 검출 |
확인 방법: 포장 전면 ‘고칼슘’·‘마더구스’ 로고, 위 소비기한이 보이면 즉시 폐기·환불 대상입니다.


2. 사건 개요│충북에서 시작된 살모넬라 집단감염
5 월 15 일 충북 청주·진천 급식소에서 첫 설사·구토 환자가 나오자 질병관리청이 역학조사에 착수,
두 빵에서 동일 유전형 살모넬라균을 확인했습니다.
6 월 5 일 식약처가 전량 회수·폐기 명령을 내렸지만 같은 제품이 세종·전북 부안 급식소에도 납품되며 환자 208명으로 확산-중입니다.
3. 지역별 환자 현황 지도 & 통계
| 지역 | 첫 발생 | 확정 환자수 | 제공 제품 |
| 충북 청주 | 5/15 | 120명 | 딸기크림 롤케이크 · 초코바나나빵 |
| 충북 진천 | 5/15 | 35명 | 딸기크림 롤케이크 · 초코바나나빵 |
| 세종 | 5/16 | 18명 | 딸기크림 롤케이크 |
| 전북 부안 | 5/15 | 35명 | 딸기크림 롤케이크 |
질병청은 동일 제품을 받은 170여 급식소를 전수 모니터링하며 추가 증상 보고를 받고 있습니다.
4. 회수·환불 절차 총정리
- 사진 촬영 – 제품 앞·뒷면, 소비기한이 보이도록 찍기
- 반납 – 납품업체·학교·어린이집 등에 제출 → 당일 환불
- 개별 구매자 – 영수증 없이도 패키지 실물만 있으면 푸드머스 고객센터(080-022-0085) 통해 택배 회수 가능
- 병원비 보상 – 진단서·영수증 첨부 시 식품사고 배상책임보험으로 100 % 환급
5. 살모넬라 감염 증상 & 병원 선택 가이드
- 잠복기 6~72 시간
- 주요 증상 고열·심한 설사·구토·복통·근육통
- 응급 기준 하루 6회 이상 수분 설사·혈변·소아·고령·임산부
- 진료 과목 소아청소년과·소화기내과·응급실
- 평균 치료비 3만~7만 원 → 실손보험 청구 가능

6. 고칼슘 딸기크림 롤케이크·초코바나나빵 3초 구별법
- ‘고칼슘’ 문구 울트라 실버 라벨
- 제조사 마더구스 표기
- 소비기한 09-21 / 10-12 ‘둘 중 하나’면 문제 제품

7. 예방 꿀팁│위생 5계명
- 냉장 4 °C 이하, 재고 24 시간 안 소비
- 달걀·밀가루 취급 후 75 °C 이상 열탕 세척
- 급식소 주 1회 위생 점검표 공개 요구
- 유증상자 2인 이상 → 즉시 보건소 신고 의무
- 환자 발생 장소 10 mL/ℓ 차염소산나트륨 소독 후 30분 환기
8. FAQ
- Q. 먹었는데 무증상입니다. 회수 대상인가요?
A. 소비기한·포장 일치 시 증상 유무와 관계없이 반드시 환불·폐기하세요. - Q. 냉동 보관했으면 안전할까요?
A. 살모넬라는 -18 °C 냉동에서도 생존 → 폐기 권장. - Q. 학교 급식 환불은 누가 처리하나요?
A. 급식 위탁업체가 선보상 후 푸드머스에 구상청구합니다. 학부모는 학교 행정실에 신청하면 됩니다.
핵심 요약
‘고칼슘 딸기크림 롤케이크’·‘고칼슘 우리밀 초코바나나빵’ 살모넬라 검출 → 충북·세종·부안 208명 환자 → 식약처 전량 회수·환불 진행! 포장·소비기한 확인하고 증상 땐 즉시 진료하기.
‘이렇게’ 했더니 2분 만에 꿀잠… 美연구진도 놀란 수면법 공개!
‘이렇게’ 했더니 2분 만에 꿀잠… 美연구진도 놀란 수면법 공개! 안녕하세요, 자유소유입니다 😊“잠이 안 와요...” 한밤중 뒤척이며 스마트폰만 들여다보신 적 있으시죠?그런데, 최근 미국
yousoyou.co.kr
노화를 최소 10년 늦춘다는 ‘이 습관’, 의사들이 먼저 실천하는 이유
노화를 최소 10년 늦춘다는 ‘이 습관’, 의사들이 먼저 실천하는 이유 – 수면, 식습관, 운동만 챙겨도 인생이 달라집니다안녕하세요, 자유소유입니다 😊"늙는 게 두렵다"는 말, 다들 한 번쯤
yousoyou.co.kr
“죽기 직전, 100명 중 97명이 똑같이 남긴 마지막 한마디”
“죽기 직전, 100명 중 97명이 똑같이 남긴 마지막 한마디” 안녕하세요, 자유소유입니다.오늘은 삶의 마지막 순간에 사람들이 남긴 '마지막 한마디'에 대해 이야기해보려 합니다. 사람은 떠나는
yousoyou.co.kr
“부동산으로 노후 망친 3가지 실수 – 절대 하면 안 되는 선택”
“부동산으로 노후 망친 3가지 실수 – 절대 하면 안 되는 선택” 안녕하세요, 자유소유입니다 😊오늘은 "부동산으로 노후 망친 3가지 실수 – 절대 하면 안 되는 선택"이라는 주제로 이야기해
yousoyou.co.kr
당신이 자녀에게 바치는 그 사랑, 혹시 독이 되고 있진 않나요?
당신이 자녀에게 바치는 그 사랑, 혹시 독이 되고 있진 않나요?안녕하세요, 자유소유입니다 😊오늘은 "당신이 자녀에게 바치는 그 사랑, 혹시 독이 되고 있진 않나요?"라는 주제로 이야기해보려
yousoyou.co.kr
7일 동안 당근 한 개씩만 먹었더니, 뱃살 실종! 속는셈치고 보세요
7일 동안 당근 한 개씩만 먹었더니, 뱃살 실종! 속는셈치고 보세요안녕하세요, 자유소유입니다 😊솔직히 말해서 ‘당근 한 개’로 뱃살이 빠진다고요? 처음엔 저도 반신반의했어요.그런데요…
yousoyou.co.kr
'이슈 인사이트' 카테고리의 다른 글
| 김현종 국가안보실 1차장 프로필:전 국방개혁비서관 경력 부터 임명배경까지 정리 (1) | 2025.06.15 |
|---|---|
| 이명현 변호사 프로필 공개! 학력·경력·채해병 특검 임명 이유까지 (2) | 2025.06.14 |
| 김병기 프로필 정리 | ‘친명 원내대표’ 선출 배경과 리즈시절 결혼사진까지 (2) | 2025.06.13 |
| 송기호 프로필 총정리: 국정상황실장 임명된 변호사 출신 이력 공개 (2) | 2025.06.13 |
| 황보승희 프로필:남편 조성화 누구? 정치자금 스캔들까지 정리 (2) | 2025.06.13 |